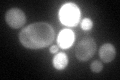
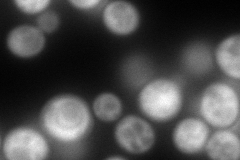
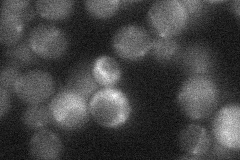

View description
Phenylpyruvate decarboxylase, catalyzes decarboxylation of phenylpyruvate to phenylacetaldehyde, which is the first specific step in the Ehrlich pathway
Localization:
Intensity:
Fold change:
Significance:
-
C’ GFP library in SD
cytosol107.46 -
N' NOP1pr-GFP in SD

cytosol184.344 -
N' TEF2pr-mCherry in SD
cytosol217.939 -
N' NATIVEpr-GFP in SD
below threshold23.1417 -
N' TEF2pr-VC and Cyto-VN in SD

cytosol59.6903 -
C’ GFP library in SD+DTT

cytosol37.570.34Yes -
C’ GFP library in SD+H2O2

cytosol113.261.05No -
C’ GFP library in Starvation Media

cytosol15.920.14No -
C’ GFP library on the background of Pup2-DaMP

cytosol -
C’ GFP library on the background of CCT mutant

cytosol115.0581.07061No
